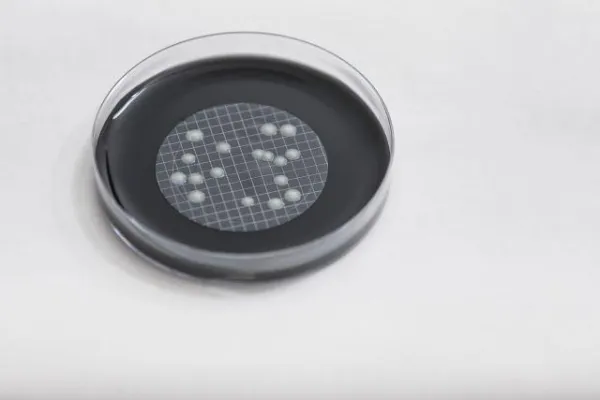
Bild: Vorarlberg führt Legionellen-Statistik an

(openPR) Vorarlbergs größter Anbieter von Gebäudetechnik-Service investiert in Heiztechnik-Know-how
Die TGS Technischer Gebäude Service GmbH in Altach übernimmt per Anfang Juli das Dornbirner Wärmetechnik-Unternehmen von Ioannis Konstantinou. Damit sichert sich TGS das Know-how für Örtli- und Hydrotherm-Heizungsanlagen und erweitert sein Leistungsspektrum.
Ab Anfang Juli wird die Konstantinou Wärmetechnik aus Dornbirn in die TGS Technischer Gebäude Service GmbH in Altach übernommen. Die Marke bleibt dabei erhalten und Inhaber Ioannis Konstantinou wird seine 1991 begonnene Arbeit als Spezialist für Heizungsanlagen der Marken Örtli und Hydrotherm bei TGS fortsetzen. Das Angebot von Konstantinou Wärmetechnik umfasst derzeit Verkauf, Service und Reparatur von Öl- und Gasbrennern, Öl- und Gasbrennwertkesseln, Regelungstechnik, Boilern, Speichern, Solaranlagen, Holzvergasern sowie Heizwertkesseln.
Kooperation auf Augenhöhe
TGS ist der größte Servicedienstleister für Gebäudetechnik in Vorarlberg. Für TGS-Gründer Peter Schelling ist die künftige Zusammenarbeit ein logischer Schritt: „Unsere Mission ist umfassender Service für Gebäudetechnik. Durch Ioannis Konstantinou können wir unser Spektrum um Örtli- und Hydrotherm-Heizungsanlagen erweitern.“ Und auch die bestehenden Kunden von Konstantinou Wärmetechnik profitieren von der Zusammenarbeit: „Künftig kann ich mit TGS als Partner Leistungen über die Wärmetechnik hinaus anbieten“, freut sich Ioannis Konstantinou. Nachdem Hydrotherm-Anlagen nicht mehr hergestellt werden, kann Kunden auch beim Ausfall der Anlage mit einer zukunftssicheren Ersatzlösung geholfen werden.
Win-win-Situation für Kunden
Hinsichtlich Heizung wird sich für die Kunden von Konstantinou Wärmetechnik nichts ändern. Sie werden mit ihren Örtli- oder Hydrotherm-Anlage nach wie vor von ihrem bekannten Spezialisten betreut. Auch die Marke bleibt bestehen. Das ist den Beteiligten wichtig: „Wir wollen den Kunden von Ioannis Konstantinou die Sicherheit geben, dass die neue Partnerschaft für sie vorteilhaft ist. Neben dem gewohnten Service können sie auch auf das volle TGS-Leistungsspektrum zugreifen“, erklärt Peter Schelling.
Website: www.tgs.co.at